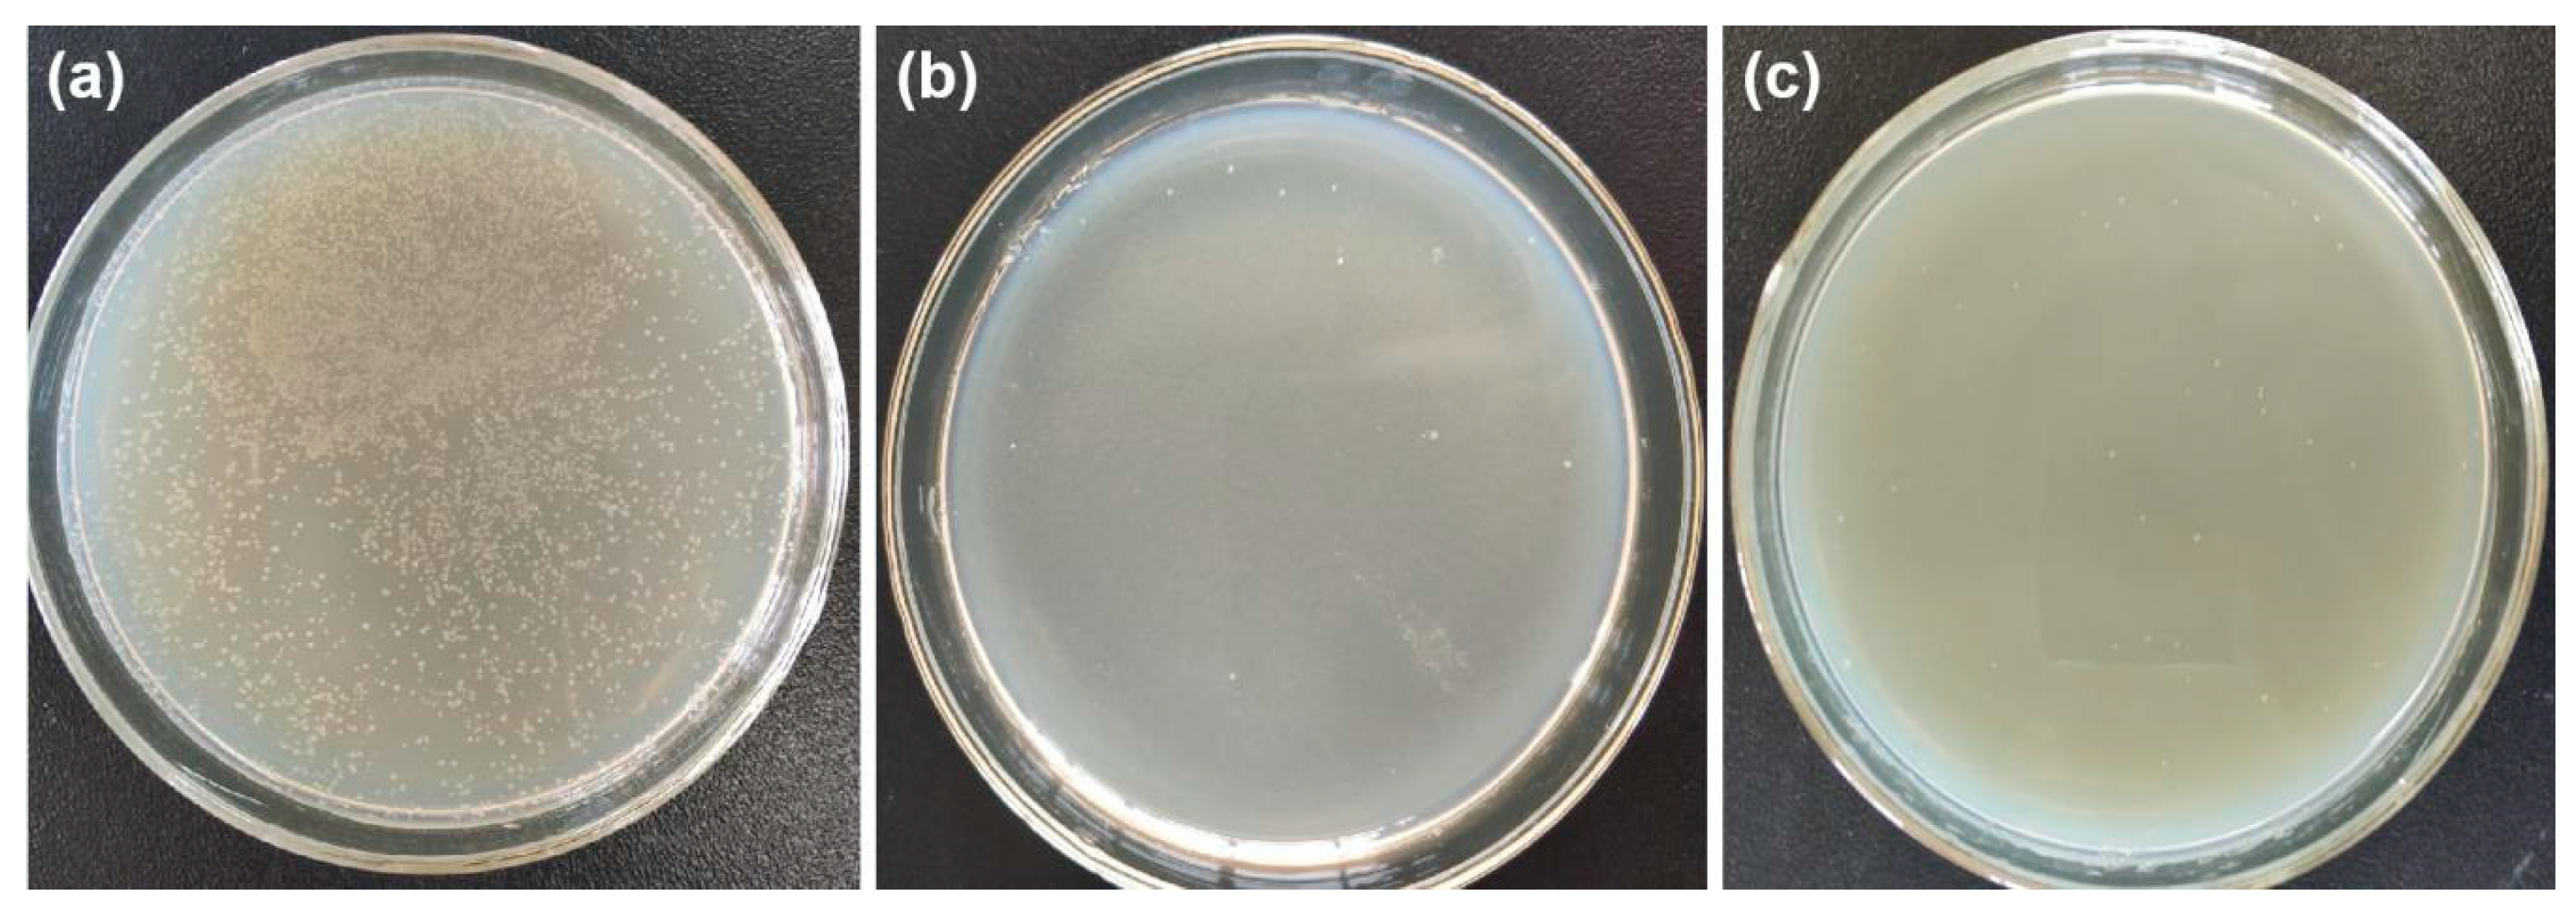
Polymers 12 00783 g011 Polymers 12 00783 g011

Ag NPs-Assisted Synthesis of Stable Cu NPs on PET Fabrics for Antibacterial and Electromagnetic Shielding Performance
Abstract
1. Introduction
2. Materials and Methods
2.1. Materials
2.2. Preparation
2.3. Characterization and Measurements
2.4. Electromagnetic Field Performance
3. Results and Discussion
3.1. Morphology
3.2. Elemental Analysis
3.3. XRD Pattern
3.4. Thermal Analysis
3.5. Durability
3.6. Antibacterial Activity
3.7. Electromagnetic Field Performance
4. Conclusions
Author Contributions
Funding
Acknowledgments
Conflicts of Interest
References
- Sataev, M.S.; Koshkarbaeva, S.T.; Tleuova, A.B.; Perni, S.; Aidarova, S.B.; Prokopovich, P. Novel process for coating textile materials with silver to prepare antimicrobial fabrics. Colloid Surface A 2014, 442, 146–151. [Google Scholar] [CrossRef]
- Emam, H.E.; Abdelhameed, R.M. Anti-UV radiation textiles designed by embracing with nano-MIL (Ti, In)–metal organic framework. ACS Appl. Mater. Interfaces 2017, 9, 28034–28045. [Google Scholar] [CrossRef] [PubMed]
- Chen, H.C.; Lee, K.C.; Lin, J.H.; Koch, M. Fabrication of conductive woven fabric and analysis of electromagnetic shielding via measurement and empirical equation. J Mater. Process. Tech. 2007, 184, 124–130. [Google Scholar] [CrossRef]
- Jiang, S.X.; Guo, R.H. Electromagnetic shielding and corrosion resistance of electroless Ni–P/Cu–Ni multilayer plated polyester fabric. Surf. Coat. Tech. 2011, 205, 4274–4279. [Google Scholar] [CrossRef]
- Šimor, M.; Černák, M.; Imahori, Y. Atmospheric-pressure plasma treatment of polyester nonwoven fabrics for electroless plating. Surf. Coat. Tech. 2003, 172, 1–6. [Google Scholar] [CrossRef]
- Jiang, S.Q.; Newton, E.; Yuen, C.W.M. Chemical silver plating on cotton and polyester fabrics and its application on fabric design. Text. Res. J. 2006, 76, 57–65. [Google Scholar] [CrossRef]
- Yuen, C.W.M.; Jiang, S.Q.; Kan, C.W. Influence of surface treatment on the electroless nickel plating of textile fabric. Appl. Surf. Sci. 2007, 253, 5250–5257. [Google Scholar] [CrossRef]
- Shen, Y.; Zhang, H.F.; Wang, L.M. Fabrication of electromagnetic shielding polyester fabrics with carboxymethyl chitosan-palladium complexes activation. Fiber. Polym. 2014, 15, 1414–1421. [Google Scholar] [CrossRef]
- Wu, D.; Zhang, T.; Wang, W.C. Reflective and conductive surface-silvered polyimide films prepared by surface graft copolymerization and electroless plating. Polym. Advan. Technol. 2008, 19, 335–341. [Google Scholar] [CrossRef]
- Cai, X.; Yuan, J.; Chen, S. Hemocompatibility improvement of poly (ethylene terephthalate) via self-polymerization of dopamine and covalent graft of zwitterions. Mat. Sci. Eng. C 2014, 36, 42–48. [Google Scholar] [CrossRef]
- Nielsen, S.R.; Besenbacher, F.; Chen, M. Mussel inspired surface functionalization of electrospun nanofibers for bio-applications. Phys. Chem. Chem. Phys. 2013, 15, 17029–17037. [Google Scholar] [CrossRef] [PubMed]
- Lynge, M.E.; Westen, R.; Postma, A. Polydopamine-a nature-inspired polymer coating for biomedical science. Nanoscale 2011, 3, 4916–4928. [Google Scholar] [CrossRef] [PubMed]
- Ku, S.H.; Park, C.B. Human endothelial cell growth on mussel-inspired nanofiber scaffold for vascular tissue engineering. Biomaterials 2010, 31, 9431–9437. [Google Scholar] [CrossRef] [PubMed]
- Song, Y.; Ye, G.; Wu, F. Bioinspired polydopamine (PDA) chemistry meets ordered mesoporous carbons (OMCs): a benign surface modification strategy for versatile functionalization. Chem. Mater. 2016, 28, 5013–5021. [Google Scholar] [CrossRef]
- Wang, Y.; Shang, B.; Hu, X. Temperature Control of Mussel-Inspired Chemistry toward Hierarchical Superhydrophobic Surfaces for Oil/Water Separation. Adv. Mater. Interfaces 2017, 4, 1600727. [Google Scholar] [CrossRef]
- Lu, Z.; Xiao, J.; Wang, Y. In situ synthesis of silver nanoparticles uniformly distributed on polydopamine-coated silk fibers for antibacterial application. J Colloid Interf. Sci. 2015, 452, 8–14. [Google Scholar] [CrossRef]
- Ran, J.; He, M.; Li, W. Growing ZnO nanoparticles on polydopamine-templated cotton fabrics for durable antimicrobial activity and UV protection. Polymers 2018, 10, 495. [Google Scholar] [CrossRef]
- Xu, Z.; Miyazaki, K.; Hori, T. Fabrication of polydopamine-coated superhydrophobic fabrics for oil/water separation and self-cleaning. Appl. Surf. Sci. 2016, 370, 243–251. [Google Scholar] [CrossRef]
- Yang, J.; Xu, H.; Zhang, L. Lasting superhydrophobicity and antibacterial activity of Cu nanoparticles immobilized on the surface of dopamine modified cotton fabrics. Surf. Coat. Tech. 2017, 309, 149–154. [Google Scholar] [CrossRef]
- Zou, L.; Lan, C.; Li, X.; Zhang, S.; Qiu, Y.; Ma, Y. Superhydrophobization of cotton fabric with multiwalled carbon nanotubes for durable electromagnetic interference shielding. Fiber. Polym. 2015, 16, 2158–2164. [Google Scholar] [CrossRef]
- Ghosh, S.; Mondal, S.; Ganguly, S. Carbon nanostructures based mechanically robust conducting cotton fabric for improved electromagnetic interference shielding. Fiber. Polym. 2018, 19, 1064–1073. [Google Scholar] [CrossRef]
- Zhang, L.; Gao, R.; Hu, P. Preparation and dielectric properties of polymer composites incorporated with polydopamine@ AgNPs core–satellite particles. RSC Adv. 2016, 6, 34529–34533. [Google Scholar] [CrossRef]
- Tang, Y.; Yuan, H.; Chen, J. Polydopamine-Assisted Fabrication of Stable Silver Nanoparticles on Optical Fiber for Enhanced Plasmonic Sensing. Photonic Sens. 2019, 1–8. [Google Scholar] [CrossRef]
- Hu, M.X.; Guo, Q.; Li, J.N. Reduction of methylene blue with Ag nanoparticle-modified microporous polypropylene membranes in a flow-through reactor. New J. Chem. 2017, 41, 6076–6082. [Google Scholar] [CrossRef]
- Zhang, X.; Ji, J.; Zhang, X. Mussel inspired modification of carbon nanotubes using RAFT derived stimuli-responsive polymers. RSC Adv. 2013, 3, 21817–21823. [Google Scholar] [CrossRef]
- Zhang, Z.; Si, T.; Liu, J.; Han, K.; Zhou, G. Controllable synthesis of AgNWs@PDA@AgNPs core-shell nanocobs based on a mussel-inspired polydopamine for highly sensitive SERS detection. RSC Adv. 2018, 8, 27349–27358. [Google Scholar] [CrossRef]
- Choi, J.; Oh, H.; Han, S.W.; Ahn, S.; Noh, J.; Park, J.B. Preparation and characterization of graphene oxide supported Cu, Cu2O, and CuO nanocomposites and their high photocatalytic activity for organic dye molecule. Curr. Appl. Phys. 2017, 17, 137–145. [Google Scholar] [CrossRef]
- Xu, W.Z.; Yuan, X.H.; Wei, A.F. Characterisation of PET nonwoven deposited with Ag/FC nanocomposite films. Surf. Eng. 2018, 34, 838–845. [Google Scholar] [CrossRef]
- Li, H.; Aulin, Y.V.; Frazer, L. Structure evolution and thermoelectric properties of carbonized polydopamine thin films. ACS Appl. Mater. Interfaces 2017, 9, 6655–6660. [Google Scholar] [CrossRef]
- Van, V.P.; Phan, B.T.; Mott, D. Silver nanoparticle loaded TiO2 nanotubes with high photocatalytic and antibacterial activity synthesized by photoreduction method. J Photoch. Photobio. A 2018, 352, 106–112. [Google Scholar]
- Zheng, J.; Lin, Z.; Liu, W. One-pot synthesis of CuFe2O4 magnetic nanocrystal clusters for highly specific separation of histidine-rich proteins. J Mater. Chem. B 2014, 2, 6207–6214. [Google Scholar] [CrossRef]
- Muñoz-Bonilla, A.; Fernández-García, M. Polymeric materials with antimicrobial activity. Prog. Polym. Sci. 2012, 37, 281–339. [Google Scholar] [CrossRef]
- Muñoz-Bonilla, A.; Fernández-García, M. The roadmap of antimicrobial polymeric materials in macromolecular nanotechnology. Eur. Polym. J. 2015, 65, 46–62. [Google Scholar] [CrossRef]
- Álvarez-Paino, M.; Muñoz-Bonilla, A.; Fernández-García, M. Antimicrobial polymers in the nano-world. Nanomaterials 2017, 7, 48. [Google Scholar] [CrossRef] [PubMed]
- Rahaman, M.; Chaki, T.K.; Khastgir, D. Development of high performance EMI shielding material from EVA, NBR, and their blends:effect of carbon black structure. J Mater. Sci. 2011, 46, 3989–3999. [Google Scholar] [CrossRef]
- Han, E.G.; Kim, E.A.; Oh, K.W. Electromagnetic interference shielding effectiveness of electroless Cu-plated PET fabrics. Synthetic Met. 2001, 123, 469–476. [Google Scholar] [CrossRef]

© 2020 by the authors. Licensee MDPI, Basel, Switzerland. This article is an open access article distributed under the terms and conditions of the Creative Commons Attribution (CC BY) license (http://creativecommons.org/licenses/by/4.0/).
Share and Cite
Wang, K.; Ma, Q.; Zhang, Y.; Wang, S.; Han, G. Ag NPs-Assisted Synthesis of Stable Cu NPs on PET Fabrics for Antibacterial and Electromagnetic Shielding Performance. Polymers 2020, 12, 783. https://doi.org/10.3390/polym12040783
Wang K, Ma Q, Zhang Y, Wang S, Han G. Ag NPs-Assisted Synthesis of Stable Cu NPs on PET Fabrics for Antibacterial and Electromagnetic Shielding Performance. Polymers. 2020; 12(4):783. https://doi.org/10.3390/polym12040783
Chicago/Turabian StyleWang, Ke, Qian Ma, Yuanming Zhang, Shudong Wang, and Guangting Han. 2020. "Ag NPs-Assisted Synthesis of Stable Cu NPs on PET Fabrics for Antibacterial and Electromagnetic Shielding Performance" Polymers 12, no. 4: 783. https://doi.org/10.3390/polym12040783
APA StyleWang, K., Ma, Q., Zhang, Y., Wang, S., & Han, G. (2020). Ag NPs-Assisted Synthesis of Stable Cu NPs on PET Fabrics for Antibacterial and Electromagnetic Shielding Performance. Polymers, 12(4), 783. https://doi.org/10.3390/polym12040783

